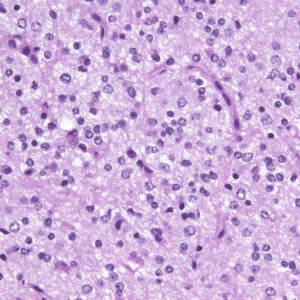

乏突起膠腫の症例と病理
1. 乏突起膠腫 グレード 2 OD oligodendroglioma
2. 退形成性乏突起膠腫 グレード 3 AO anaplastic oligodendroglioma
びまん星細胞腫との違いは石灰化
症候性てんかんのみで発症した右側頭葉と島回のグレード2オリゴです。左のT2,中央のフレアではグレード2びまん性星細胞腫と鑑別はできません。認知機能などは正常でした。
何と言っても診断的価値があるのは 石灰化 carcification です。左のCTの中央にみえる白い部分が石灰化です。この程度の石灰化でも診断的な価値があります。1p/19q codeletionがあるオリゴでした。病理では,均一な小型の円形核を有する細胞と多数の毛細血管 chickin-wire network がみられます。部分摘出後,放射線治療とテモゾロマイド化学療法でコントロールできています。
極めて高度な石灰化:脳石 brain stone
左は通常のCT,右は骨条件CTです。左前頭葉に巨大な石灰化を伴う乏突起膠腫があります。病理組織像は基本的にはグレード2です。石の塊のようにみえるので braine stoneと呼ばれ,CT eraでは oligodendrogliomaの hallmarkと言われました。
良性の経過を辿る乏突起膠腫の例
必ずしも大量の放射線治療や化学療法をしなくてもよい例があることを知っておいてください
グレード2:良性の乏突起膠腫の例
認知症で発症した60代男性の乏突起膠腫です。巨大で周囲の脳を圧迫する腫瘍でしたから,手術で部分摘出した後に放射線も化学療法も何もしないで経過観察しましたが,患者さんは社会復帰して仕事に戻れました。その後,無治療で13年が経過した時のMRIです。この13年間にほとんど大きくなっていません。このように高分化型とされる乏突起膠腫には,何もしないで様子を見ても長期間にわたって増大しない良性のものもあります。
良い経過を辿った小児の乏突起膠腫の例
これは4歳の女の子の左の視床にできた乏突起膠腫です。コンピュータガイドの定位脳手術という方法で生検術をしました。病理像はやはり高分化型なのですが,大きくなると困る場所なので,半定位放射線治療を46グレイあてました。MRIの左側は放射線治療前,右側は放射線治療6年後のものです。腫瘍は縮小したままで再燃せず,10年以上経過しますが元気に学校へ行っています。視床下部へ照射が入ったので思春期早発を生じました。
病理所見では,典型的な小さな円形核とその周囲が抜けてみえる perinuclear hallo (fried egg appearance)と細血管の chicken wire appearanceが見られます。
良性の乏突起膠腫の巨大なもの
これは30歳くらいの若い女性にできた乏突起膠腫です。軽いけいれん発作を生じましたがその後は無症状です。上がT2強調画像で,下がガドリニウム増強像です。CTでは石灰化が散在していました。大脳深部をほとんど埋めるように腫瘍は浸潤して広がっています。脳外科の先生にこの患者さんが無症状だといっても信じてもらえないのですが本当です。
ほんの少しだけ腫瘍をとって(生検術)病理診断を確定しました。
HE染色では,perinuclear haloをもった小型の腫瘍細胞が見られ,また右ではminigemistcyteと呼ばれる小さいけれどeoginophiricな胞体の豊かな腫瘍細胞の出現があり,典型的な乏突起膠腫の像です。
左に細かい石灰化が見られます。右は,グレード2の乏突起膠腫には珍しい血管内皮の増生 gromerulation なのですが,必ずしも悪性像とはいえません。通常の乏突起膠腫と同様にchicken wireと呼ばれるような細かい腫瘍血管網も存在しました。
上から順番に,GFAP染色,OLIG2染色,MIB-1染色 (2%以下) です。
腫瘍が大きすぎるので,認知機能を保つために,全脳照射30グレイとテモゾロマイド化学療法を2年しました。以来9年以上たちますが,とても頭の良い方でちゃんと働いておられます。
この患者さんから学ぶことはたくさんあります。この広範に伸展した腫瘍はおそらく10歳前後から存在したのだと想像されます。腫瘍が発見されず未治療だったからこそ,これまで通常の生活ができたのかもしれません。
また,グレード2の乏突起膠腫には限りなくグレード1に近い高分化型の腫瘍が存在するということです。乏突起膠腫は手術で完全摘出できれば治るのでしょうが,手術によって認知機能障害や高次脳機能障害を生じれば社会生活を一人ですることは難しくなります。分化型の乏突起膠腫は,正常の神経細胞や脳機能を破壊しないで浸潤増大しますから,脳の中にこんなに広がっても,何の症状も出さないということがあります。同じグリオーマでも膠芽腫などと比べれば大きな差があるのです。治療後の生存の質を考える時に,このような例があるということを思い出すことは大切です。
乏突起星細胞腫 oligoastrocytoma, NOS グレード2:てんかん例
強直発作tonic seizureと夜間の嘔気発作で発症した女の子の乏突起星細胞腫です。海馬鉤と扁桃体を侵す内側側頭葉神経膠腫 mesial temporal gliomaと呼ばれる腫瘍です。特に小児に難治性てんかんを生じることで有名です。
T2強調画像とフレア画像でまだらな高信号を示しますが,境界は比較的明瞭です。限局性グリオーマ localized gliomaと呼ばれるタイプです。
CTでもMRIでも全く増強されません。
病理像です。左側の部分はperinuclear hallowが多い典型的な乏突起膠腫です。右側の部分ではびまん性星細胞腫の像ですが,その中に乏突起膠腫に特徴的なchicken wireと呼ばれる細い血管網も見られます。乏突起星細胞腫と呼ばれるのですが、腫瘍性格は乏突起膠腫と同じもので,星細胞系腫瘍には入りません。1p/19q欠失があるもののIDH変異がないのでoligoastrocytoma, NOSです。

術後のMRIです。腫瘍は全摘できていて再発はありません。手術でとても大切なことは,てんかん原性のある海馬鉤の腫瘍を摘出するだけではなくて,扁桃体切除 amygdalectomyも加えることです。それによって症候性てんかんをmedication freeにもっていける可能性があがります。扁桃体は片側(この場合は左)切除しても症状は出ません。
取れない場所の乏突起膠腫への低線量放射線治療とテモゾロマイド
壮年男性の乏突起膠腫 グレード2です。右の運動野(中心前回)に入っているので完全摘出はできません。

前方の上前頭回のわずかな部分摘出をして,手術後に46グレイ23分割の局所放射線治療とテモゾロマイドの併用治療しました。それから,テモゾロマイドを4週間に一回投与して,24コース,2年間続けました。左のMRIは9年後の画像です。腫瘍は消失していないのですが,ずっと同じ状態です (DS disease stablilized)。
乏突起膠腫は予後が良いので,大きな線量の放射線治療は使用したくありません。46Gyは最低線量でしょう。照射の減量分を2年間のテモゾロマイドで補えるかもしれません。でもこの治療方法の確実性は科学的に証明されていません。
1p/19q loss1のある退形成性乏突起膠腫は化学療法感受性が高い
グリオーマなので,「化学療法では簡単に縮小しないであろう」と思われる方に実例をお見せします。とても古い例で,2001年の例ですからテモゾロマイドもCCNU (PCV) も使用できませんでした。
若い成人です,認知機能障害で発症しました。この画像を見るからに悪性神経膠腫,少なくともグレード3のグリオーマであることは明白です。しかし,グレード4膠芽腫あるいはグレード3退形成性星細胞腫にしては腫瘍周辺浮腫が軽すぎます。ですから,グレード3の退形成性乏突起膠腫 AO かも。認知機能の回復と温存を考量して,脳梁損傷と前交連損傷を避けて,右上前頭回と帯状回腫瘍を摘出しました。
左は術後のT1強調ガドリニウム増強像で,残存腫瘍がわかります。この腫瘍に対してICE (IFO/CDDP/VP-16) 化学療法を1コースしました。右側のMRIが1ヶ月後の画像です。このように1p/19q欠失のある退形成性乏突起膠腫は,化学療法感受性がとても高い悪性グリオーマです。ですから,手術で後遺症を残さないように,勢い込んで腫瘍を摘出しようとしないことが大切です。光顕診断はAOで,後々の解析で1p/19q codeletion でした。
遠隔再発 remote recurrence
乏突起膠腫には局所放射線治療が用いられます。でも,予想外に離れた部位から再発してしまうことがあります。とても珍しい現象なので通常の臨床では考慮に入れません。
35歳,側頭葉てんかんで発症した右側頭葉の乏突起膠腫 グレード2です。全摘出して化学療法4コースと54グレイの局所放射線治療 generous local fieldを行いました。7年後に同じ部位に再発して摘出したところ退形成性乏突起膠腫 グレード3となっていました。手術摘出して,テモゾロマイド化学療法で維持療法をしていました。
その2年後の画像です。右小脳半球に再発しています。右側頭葉腫瘍との連続性は全くありませんでした。脳幹部にも腫瘍はありません。遠隔再発 remote recurrenceというもので,星細胞系腫瘍 astroytic tumor AAやGBMではよく知られている現象です。乏突起膠細胞系腫瘍でもまれにみられます。
だからと言って初期治療で広範囲放射線治療をした方がいいということにはならず,これを避ける手段はありません。